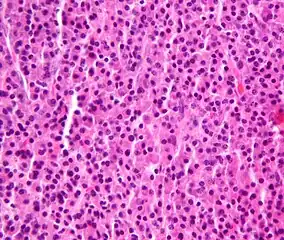
Plasmacytoma, H&E stain

Multiple myeloma
| Multiple myeloma | |
|---|---|
| Other names: Plasma cell myeloma, myelomatosis, Kahler's disease, myeloma[1] | |
  | |
| Top: The most common site of bone lesions is the spine Bottom: Micrograph of a plasmacytoma, H&E stain | |
| Specialty | Hematology and oncology |
| Symptoms | Bone pain, bleeding, frequent infections, anemia[2] |
| Complications | Amyloidosis, kidney problems, bone fractures, overly thick blood[2][3] |
| Duration | Long term[3] |
| Causes | Unknown[4] |
| Risk factors | Obesity[5] |
| Diagnostic method | Blood or urine tests, bone marrow biopsy, medical imaging[6] |
| Treatment | Steroids, chemotherapy, thalidomide, stem cell transplant, bisphosphonates, radiation therapy[3][6] |
| Prognosis | Five-year survival rate 52% / life expectancy 6 years (USA)[7] |
| Frequency | 488,200 (affected during 2015)[8] |
| Deaths | 101,100 (2015)[9] |
Multiple myeloma (MM), also known as plasma cell myeloma and simple myeloma, is a cancer of plasma cells, a type of white blood cell that normally produces antibodies.[6] Often, no symptoms are noticed initially.[2] As it progresses, bone pain, bleeding, frequent infections, and anemia may occur.[2] Complications may include amyloidosis.[3]
The cause of multiple myeloma is unknown.[4] Risk factors include obesity, radiation exposure, family history, and certain chemicals.[5][10][11] Multiple myeloma may develop from monoclonal gammopathy of undetermined significance that progresses to smoldering myeloma.[12] The abnormal plasma cells produce abnormal antibodies, which can cause kidney problems and overly thick blood.[2] The plasma cells can also form a mass in the bone marrow or soft tissue.[2] When one tumor is present, it is called a plasmacytoma; more than one is called multiple myeloma.[2] Multiple myeloma is diagnosed based on blood or urine tests finding abnormal antibodies, bone marrow biopsy finding cancerous plasma cells, and medical imaging finding bone lesions.[6] Another common finding is high blood calcium levels.[6]
Multiple myeloma is considered treatable, but generally incurable.[3] Remissions may be brought about with steroids, chemotherapy, targeted therapy, and stem cell transplant.[3] Bisphosphonates and radiation therapy are sometimes used to reduce pain from bone lesions.[3][6]
Globally, multiple myeloma affected 488,000 people and resulted in 101,100 deaths in 2015.[8][9] In the United States, it develops in 6.5 per 100,000 people per year and 0.7% of people are affected at some point in their lives.[7] It usually occurs around the age of 60 and is more common in men than women.[6] It is uncommon before the age of 40.[6] Without treatment, typical survival is seven months.[3] With current treatments, survival is usually 4–5 years.[3] The five-year survival rate is about 49%.[7] The word myeloma is from the Greek myelo- meaning "marrow" and -oma meaning "tumor".[13]
Signs and symptoms
Because many organs can be affected by myeloma, the symptoms and signs vary greatly.[14] A mnemonic sometimes used to remember some of the common symptoms of multiple myeloma is CRAB: C = calcium (elevated), R = renal failure, A = anemia, B = bone lesions.[15] Myeloma has many other possible symptoms, including opportunistic infections (e.g., pneumonia) and weight loss.
Bone pain
Bone pain affects almost 70% of people with multiple myeloma and is the most common symptom.[16] Myeloma bone pain usually involves the spine and ribs, and worsens with activity. Persistent, localized pain may indicate a pathological bone fracture. Involvement of the vertebrae may lead to spinal cord compression or kyphosis. Myeloma bone disease is due to the overexpression of receptor activator for nuclear factor κ B ligand (RANKL) by bone marrow stroma. RANKL activates osteoclasts, which resorb bone. The resultant bone lesions are lytic (cause breakdown) in nature, and are best seen in plain radiographs, which may show "punched-out" resorptive lesions (including the "raindrop" appearance of the skull on radiography). The breakdown of bone also leads to the release of calcium ions into the blood, leading to hypercalcemia and its associated symptoms.
Anemia
The anemia found in myeloma is usually normocytic and normochromic. It results from the replacement of normal bone marrow by infiltrating tumor cells and inhibition of normal red blood cell production (hematopoiesis) by cytokines.
Impaired kidney function
Impaired kidney function may develop, either acutely or chronically, and with any degree of severity.

The most common cause of kidney failure in multiple myeloma is due to proteins secreted by the malignant cells. Myeloma cells produce monoclonal proteins of varying types, most commonly immunoglobulins (antibodies) and free light chains, resulting in abnormally high levels of these proteins in the blood. Depending on the size of these proteins, they may be excreted through the kidneys. Kidneys can be damaged by the effects of proteins or light chains. Increased bone resorption leads to hypercalcemia and causes nephrocalcinosis, thereby contributing to the kidney failure. Amyloidosis is a distant third in the causation. People with amyloidosis have high levels of amyloid protein that can be excreted through the kidneys and cause damage to the kidneys and other organs.[17][18]
Light chains produce myriad effects that can manifest as the Fanconi syndrome (type II kidney tubular acidosis).[17]
Infection
The most common infections are pneumonias and pyelonephritis. Common pneumonia pathogens include S. pneumoniae, S. aureus, and K. pneumoniae, while common pathogens causing pyelonephritis include E. coli and other Gram-negative organisms. The greatest risk period for the occurrence of infection is in the initial few months after the start of chemotherapy.[19] The increased risk of infection is due to immune deficiency. Although the total immunoglobulin level is typically elevated in multiple myeloma, the majority of the antibodies are ineffective monoclonal antibodies from the clonal plasma cell. A selected group of people with documented hypogammaglobulinemia may benefit from replacement immunoglobulin therapy to reduce the risk of infection.[20]
Neurological symptoms
Some symptoms (e.g., weakness, confusion, and fatigue) may be due to anemia or hypercalcemia. Headache, visual changes, and retinopathy may be the result of hyperviscosity of the blood depending on the properties of the paraprotein. Finally, radicular pain, loss of bowel or bladder control (due to involvement of spinal cord leading to cord compression) or carpal tunnel syndrome, and other neuropathies (due to infiltration of peripheral nerves by amyloid) may occur. It may give rise to paraplegia in late-presenting cases.
When the disease is well-controlled, neurological symptoms may result from current treatments, some of which may cause peripheral neuropathy, manifesting itself as numbness or pain in the hands, feet, and lower legs.
Mouth
The initial symptoms may involve pain, numbness, swelling, expansion of the jaw, tooth mobility, and radiolucency.[21] Multiple myeloma in the mouth can mimic common teeth problems like periapical abscess or periodontal abscess, gingivitis, periodontitis, or other gingival enlargement or masses.
Cause
The cause of multiple myeloma is generally unknown.[4]
Risk factors
- Monoclonal gammopathy of undetermined significance (MGUS) increases the risk of developing multiple myeloma. MGUS transforms to multiple myeloma at the rate of 1% to 2% per year, and almost all cases of multiple myeloma are preceded by MGUS.[22]
- Smoldering multiple myeloma increases the risk of developing multiple myeloma. Individuals diagnosed with this premalignant disorder develop multiple myeloma at a rate of 10% per year for the first 5 years, 3% per year for the next 5 years, and then 1% per year.[23][24]
- Obesity is related to multiple myeloma with each increase of body mass index by five increasing the risk by 11%.[25]
Studies have reported a familial predisposition to myeloma.[26][27] Hyperphosphorylation of a number of proteins—the paratarg proteins—a tendency that is inherited in an autosomal dominant manner, appears a common mechanism in these families. This tendency is more common in African-American with myeloma and may contribute to the higher rates of myeloma in this group.[26]
Epstein-Barr virus
Rarely, Epstein-Barr virus (EBV) is associated with multiple myeloma, particularly in individuals who have an immunodeficiency due to e.g. HIV/AIDS, organ transplantation, or a chronic inflammatory condition such as rheumatoid arthritis.[28] EBV-positive multiple myeloma is classified by the World Health Organization (2016) as one form of the Epstein-Barr virus-associated lymphoproliferative diseases and termed Epstein-Barr virus-associated plasma cell myeloma. EBV-positive disease is more common in the plasmacytoma rather than multiple myeloma form of plasma cell cancer.[29] Tissues involved in EBV+ disease typically show foci of EBV+ cells with the appearance of rapidly proliferating immature or poorly differentiated plasma cells.[29] The cells express products of EBV genes such as EBER1 and EBER2.[30] While the EBV contributes to the development and/or progression of most Epstein-Barr virus-associated lymphoproliferatve diseases, its role in multiple myeloma is not known.[31] However, people who are EBV-positive with localized plasmacytoma(s) are more likely to progress to multiple myeloma compared to people with EBV-negative plasmacytoma(s). This suggest that EBV may have a role in the progression of plasmacytomas to systemic multiple myeloma.[30]
Pathophysiology
B lymphocytes start in the bone marrow and move to the lymph nodes. As they progress, they mature and display different proteins on their cell surfaces. When they are activated to secrete antibodies, they are known as plasma cells.
Multiple myeloma develops in B lymphocytes after they have left the part of the lymph node known as the germinal center. The normal cell line most closely associated with MM cells is generally taken to be either an activated memory B cell or the precursor to plasma cells, the plasmablast.[32]
The immune system keeps the proliferation of B cells and the secretion of antibodies under tight control. When chromosomes and genes are damaged, often through rearrangement, this control is lost. Often, a promoter gene moves (or translocates) to a chromosome, where it stimulates an antibody gene to overproduction.
A chromosomal translocation between the immunoglobulin heavy chain gene (on chromosome 14, locus q32) and an oncogene (often 11q13, 4p16.3, 6p21, 16q23 and 20q11[33]) is frequently observed in people with multiple myeloma. This mutation results in dysregulation of the oncogene which is thought to be an important initiating event in the pathogenesis of myeloma. The result is a proliferation of a plasma cell clone and genomic instability that leads to further mutations and translocations. The chromosome 14 abnormality is observed in about 50% of all cases of myeloma. Deletion of (parts of) chromosome 13 is also observed in about 50% of cases.
Production of cytokines[34] (especially IL-6) by the plasma cells causes much of their localised damage, such as osteoporosis, and creates a microenvironment in which the malignant cells thrive. Angiogenesis (the generation of new blood vessels) is increased.
The produced antibodies are deposited in various organs, leading to kidney failure, polyneuropathy, and various other myeloma-associated symptoms.
Epigenetic
In a study that investigated the DNA methylation profile of multiple myeloma cells and normal plasma cells, a gradual demethylation from stem cells to plasma cells was observed. The observed methylation pattern of CpG within intronic regions with enhancer-related chromatin marks in multiple myeloma is similar to undifferentiated precursor and stem cells. These results may represent a de novo epigenetic reprogramming in multiple myeloma, leading to the acquisition of a methylation pattern related to stemness.[35]
Genetics
Mutations in a number of genes have been associated with this condition.[36] These include ATM, BRAF, CCND1, DIS3, FAM46C, KRAS, NRAS and TP53.[36]
Development
The genetic and epigenetic changes occur progressively. The initial change, often involving one chromosome 14 translocation, establishes a clone of bone marrow plasma cells that causes the asymptomatic disorder MGUS, which is a premalignant disorder characterized by increased numbers of plasma cells in the bone marrow or the circulation of a myeloma protein immunoglobulin. Further genetic or epigenic changes produce a new clone of bone marrow plasma cells, usually descendant from the original clone, that causes the more serious, but still asymptomatic premalignant disorder smoldering multiple myeloma. This myeloma is characterized by a rise in the number of bone marrow plasma cells or levels of the circulating myeloma protein above that seen in MGUS.
Subsequent genetic and epigenetic changes lead to a new, more aggressive clone of plasma cells, which cause further rises in the level of the circulating myeloma protein, further rises in the number of bone marrow plasma cells, or the development of one or more of a specific set of "CRAB" symptoms, which are the basis for diagnosing malignant multiple myeloma and treating the disease.
In a small percentage of multiple myeloma cases, further genetic and epigenetic changes lead to the development of a plasma cell clone that moves from the bone marrow into the circulatory system, invades distant tissues, and thereby causes the most malignant of all plasma cell dyscrasias, plasma cell leukemia.[23][37][38] Thus, a fundamental genetic instability in plasma cells or their precursors leads to the progression:
Being asymptomatic, monoclonal gammapathy of undetermined significance and smoldering multiple myeloma are typically diagnosed fortuitously by detecting a myeloma protein on serum protein electrophoresis tests done for other purposes. MGUS is a relatively stable condition afflicting 3% of people aged 50 and 5% of people aged 70; it progresses to multiple myeloma at a rate of 0.5-1% cases per year; smoldering multiple myeloma does so at a rate of 10% per year for the first 5 years, but then falls off sharply to 3% per year for the next 5 years and thereafter to 1% per year.[23][24]
Overall, some 2-4% of multiple myeloma cases eventually progress to plasma cell leukemia.[37]
Diagnosis
The presence of unexplained anemia, kidney dysfunction, a high erythrocyte sedimentation rate, lytic bone lesions, elevated beta-2 microglobulin, or a high serum protein (especially raised globulins or immunoglobulin) may prompt further testing.
Blood tests

The globulin level may be normal in established disease. A doctor may request protein electrophoresis of the blood and urine, which might show the presence of a paraprotein (monoclonal protein, or M protein) band, with or without reduction of the other (normal) immunoglobulins (known as immune paresis). One type of paraprotein is the Bence Jones protein, which is a urinary paraprotein composed of free light chains. Quantitative measurements of the paraprotein are necessary to establish a diagnosis and to monitor the disease. The paraprotein is an abnormal immunoglobulin produced by the tumor clone.
In theory, multiple myeloma can produce all classes of immunoglobulin, but IgG paraproteins are most common, followed by IgA and IgM. IgD and IgE myeloma are very rare. In addition, light and or heavy chains (the building blocks of antibodies) may be secreted in isolation: κ- or λ-light chains or any of the five types of heavy chains (α-, γ-, δ-, ε- or μ-heavy chains). People without evidence of a monoclonal protein may have "nonsecretory" myeloma (not producing immunoglobulins); this represents about 3% of all people with multiple myeloma.[39]
Additional findings may include a raised calcium level (when osteoclasts are breaking down bone, releasing it into the bloodstream), raised serum creatinine level due to reduced kidney function, which is mainly due to casts of paraprotein deposition in the kidney, although the cast may also contain complete immunoglobulins, Tamm-Horsfall protein and albumin.[40]
Other useful laboratory tests include quantitative measurement of IgA, IgG, and IgM to look for immune paresis, and beta-2 microglobulin, which provides prognostic information. On peripheral blood smear, the rouleaux formation of red blood cells is commonly seen, though this is not specific.
The recent introduction of a commercial immunoassay for measurement of free light chains potentially offers an improvement in monitoring disease progression and response to treatment, particularly where the paraprotein is difficult to measure accurately by electrophoresis (for example in light chain myeloma, or where the paraprotein level is very low). Initial research also suggests that measurement of free light chains may also be used, in conjunction with other markers, for assessment of the risk of progression from MGUS to multiple myeloma.[41]
This assay, the serum free light chain assay, has recently been recommended by the International Myeloma Working Group for the screening, diagnosis, prognosis, and monitoring of plasma cell dyscrasias.[42]
-
_HE_stain.jpg) Bone marrow aspirate showing the histologic correlate of multiple myeloma under the microscope, H&E stain
Bone marrow aspirate showing the histologic correlate of multiple myeloma under the microscope, H&E stain -
Plasmacytoma, H&E stain
Plasmacytoma, H&E stain -
 Micrograph showing myeloma cast nephropathy in a kidney biopsy: Hyaline casts are PAS positive (dark pink/red - right of image). Myelomatous casts are PAS negative (pale pink - left of image), PAS stain.
Micrograph showing myeloma cast nephropathy in a kidney biopsy: Hyaline casts are PAS positive (dark pink/red - right of image). Myelomatous casts are PAS negative (pale pink - left of image), PAS stain. -
 Atypical plasma cell infiltrate with both Russell (cytoplasmic) and Dutcher (nuclear) bodies (H&E, 50x)
Atypical plasma cell infiltrate with both Russell (cytoplasmic) and Dutcher (nuclear) bodies (H&E, 50x)
Histopathology
A bone marrow biopsy is usually performed to estimate the percentage of bone marrow occupied by plasma cells. This percentage is used in the diagnostic criteria for myeloma. Immunohistochemistry (staining particular cell types using antibodies against surface proteins) can detect plasma cells that express immunoglobulin in the cytoplasm and occasionally on the cell surface; myeloma cells are often CD56, CD38, CD138, and CD319 positive and CD19, CD20, and CD45 negative.[15] Flow cytometry is often used to establish the clonal nature of the plasma cells, which will generally express only kappa or lambda light chain. Cytogenetics may also be performed in myeloma for prognostic purposes, including a myeloma-specific fluorescent in situ hybridization and virtual karyotype.
The plasma cells seen in multiple myeloma have several possible morphologies. First, they could have the appearance of a normal plasma cell, a large cell two or three times the size of a peripheral lymphocyte. Because they are actively producing antibodies, the Golgi apparatus typically produces a light-colored area adjacent to the nucleus, called a perinuclear halo. The single nucleus (with inside a single nucleolus with vesicular nuclear chromatin) is eccentric, displaced by an abundant cytoplasm. Other common morphologies seen, but which are not usual in normal plasma cells, include:
- Bizarre cells, which are multinucleated
- Mott cells, containing multiple clustered cytoplasmic droplets or other inclusions (sometimes confused with auer rods, commonly seen in myeloid blasts)
- Flame cells, having a fiery red cytoplasm[43][44]
Historically, the CD138 has been used to isolate myeloma cells for diagnostic purposes. However, this antigen disappears rapidly ex vivo. Recently, however, the surface antigen CD319 (SLAMF7) was discovered to be considerably more stable and allows robust isolation of malignant plasma cells from delayed or even cryopreserved samples.[45]
The prognosis varies widely depending upon various risk factors. The Mayo Clinic has developed a risk-stratification model termed Mayo Stratification for Myeloma and Risk-adapted Therapy (mSMART), which divides people into high-risk and standard-risk categories.[46] People with deletion of chromosome 13 or hypodiploidy by conventional cytogenetics, t(4;14), t(14;16), t(14;20) or 17p- by molecular genetic studies, or with a high plasma cell labeling index (3% or more) are considered to have high-risk myeloma.[47]
Medical imaging
The diagnostic examination of a person with suspected multiple myeloma typically includes a skeletal survey. This is a series of X-rays of the skull, axial skeleton, and proximal long bones. Myeloma activity sometimes appears as "lytic lesions" (with local disappearance of normal bone due to resorption). And on the skull X-ray as "punched-out lesions" (pepper-pot skull). Lesions may also be sclerotic, which is seen as radiodense.[48] Overall, the radiodensity of myeloma is between −30 and 120 Hounsfield units (HU).[49] Magnetic resonance imaging is more sensitive than simple X-rays in the detection of lytic lesions, and may supersede a skeletal survey, especially when vertebral disease is suspected. Occasionally, a CT scan is performed to measure the size of soft-tissue plasmacytomas. Bone scans are typically not of any additional value in the workup of people with myeloma (no new bone formation; lytic lesions not well visualized on bone scan).
-
 X-ray of the forearm, with lytic lesions
X-ray of the forearm, with lytic lesions -
 Skull X-ray showing multiple lucencies due to multiple myeloma
Skull X-ray showing multiple lucencies due to multiple myeloma -
 Multiple myeloma in the upper arm
Multiple myeloma in the upper arm -
 Pathological fracture of the lumbar spine due to multiple myeloma
Pathological fracture of the lumbar spine due to multiple myeloma -
A CT of the brain revealed a lytic lesion in the left temporal bone (right side of image), and petrous temporal bones involving the mastoid segment of the facial nerve canal. Red arrows: lesion; green arrow: normal contralateral facial nerve canal. The lesions are consistent with a myeloma deposit.
-
 CT scan of the lower vertebral column in a man with multiple myeloma, showing multiple osteoblastic lesions: These are more radiodense (brighter in this image) than the surrounding cancellous bone, in contrast to osteolytic lesions, which are less radiodense.
CT scan of the lower vertebral column in a man with multiple myeloma, showing multiple osteoblastic lesions: These are more radiodense (brighter in this image) than the surrounding cancellous bone, in contrast to osteolytic lesions, which are less radiodense. -
 Femur with multiple myeloma lesions
Femur with multiple myeloma lesions -
 Same femur before myeloma lesions for comparison
Same femur before myeloma lesions for comparison -
 Humerus with multiple myeloma lesions
Humerus with multiple myeloma lesions -
 Same humerus before, with just subtle lesions
Same humerus before, with just subtle lesions
Diagnostic criteria
In 2003, the IMG[15] agreed on diagnostic criteria for symptomatic myeloma, asymptomatic myeloma, and MGUS, which was subsequently updated in 2009:[50]
- Symptomatic myeloma (all three criteria must be met):
- Clonal plasma cells >10% on bone marrow biopsy or (in any quantity) in a biopsy from other tissues (plasmacytoma)
- A monoclonal protein (myeloma protein) in either serum or urine (except in cases of true nonsecretory myeloma)
- Evidence of end-organ damage felt related to the plasma cell disorder (related organ or tissue impairment, CRAB):
- HyperCalcemia (corrected calcium >2.75 mmol/l, >11 mg/dl)
- Renal failure (kidney insufficiency) attributable to myeloma
- Anemia (hemoglobin <10 g/dl)
- Bone lesions (lytic lesions or osteoporosis with compression fractures)
Note: Recurrent infections alone in a person who has none of the CRAB features is not sufficient to make the diagnosis of myeloma. People who lack CRAB features, but have evidence of amyloidosis, should be considered as amyloidosis and not myeloma. CRAB-like abnormalities are common with numerous diseases, and these abnormalities must be felt to be directly attributable to the related plasma cell disorder and every attempt made to rule out other underlying causes of anemia, kidney failure, etc.
In 2014, the IMWG updated their criteria further to include biomarkers of malignancy.[42][51] These biomarkers are >60% clonal plasma cells, a serum involved / uninvolved free light chain ratio ≥ 100 (the concentration of the involved free light chain must be ≥ 100 mg/l) and more than one focal lesion ≥ 5 mm by MRI.[42][51] Together, these biomarkers and the CRAB criteria are known as myeloma-defining events (MDEs). A person must have >10 % clonal plasma cells and any MDE to be diagnosed with myeloma.[42] The biomarker criteria were added so that smouldering people with multiple myeloma at high risk of developing multiple myeloma could be diagnosed before organ damage occurred, so they would therefore have a better prognosis.[51]
- Asymptomatic/smoldering myeloma:
- Serum M protein >30 g/l (3 g/dl) or
- Clonal plasma cells >10% on bone marrow biopsy and
- No myeloma-related organ or tissue impairment
- Monoclonal gammopathy of undetermined significance (MGUS):
- Serum paraprotein <30 g/l (3 g/dl) and
- Clonal plasma cells <10% on bone marrow biopsy and
- No myeloma-related organ or tissue impairment or a related B-cell lymphoproliferative disorder
Related conditions include solitary plasmacytoma (a single tumor of plasma cells, typically treated with irradiation), plasma cell dyscrasia (where only the antibodies produce symptoms, e.g., AL amyloidosis), and peripheral neuropathy, organomegaly, endocrinopathy, monoclonal plasma cell disorder, and skin changes.
Staging
- International staging system
The international staging system (ISS) for myeloma was published by the International Myeloma Working Group in 2005:[52]
- Stage I: β2 microglobulin (β2M) < 3.5 mg/l, albumin ≥ 3.5 g/dl
- Stage II: β2M < 3.5 mg/l and albumin < 3.5 g/dl; or β2M 3.5–5.5 mg/l, irrespective of the serum albumin
- Stage III: β2M ≥ 5.5 mg/l
Note that the ISS should be used only in people who meet diagnostic criteria for myeloma. People with MGUS and asymptomatic myeloma who have kidney dysfunction from unrelated causes such as diabetes or hypertension may have elevated β2M levels from the kidney dysfunction and cannot be considered as stage III myeloma. This is one of the limitations of the ISS. It does not really quantify tumor burden or extent unlike staging systems used in other cancers. It is more of a prognostic index rather than a true staging system. For this reason, the ISS is recommended to be used along with the Durie–Salmon staging system.
- Durie–Salmon staging system
First published in 1975, the Durie–Salmon staging system[53] is still in use. However, one of the limitations of the Durie–Salmon staging system is the subjectivity in determining the extent of bone disease.
- stage I: all of
- Hb > 10 g/dl
- normal calcium
- Skeletal survey: normal or single plasmacytoma or osteoporosis
- Serum paraprotein level < 5 g/dl if IgG, < 3 g/dl if IgA
- Urinary light chain excretion < 4 g/24h
- stage II: fulfilling the criteria of neither I nor III
- stage III: one or more of
- Hb < 8.5 g/dl
- high calcium > 12 mg/dl
- Skeletal survey - three or more lytic bone lesions
- Serum paraprotein > 7 g/dl if IgG, > 5 g/dl if IgA
- Urinary light chain excretion > 12 g/24 h
Stages I, II, and III of the Durie–Salmon staging system can be divided into A or B depending on serum creatinine:
- A: serum creatinine < 2 mg/dl (< 177 μmol/l)
- B: serum creatinine > 2 mg/dl (> 177 μmol/l)
Prevention
The risk of multiple myeloma can be reduced slightly by maintaining a normal body weight.[54]
Treatment

Treatment is indicated in myeloma with symptoms. If there are no symptoms, but a paraprotein typical of myeloma and a diagnostic bone marrow are present without end-organ damage, treatment is usually deferred or restricted to clinical trials.[56] Treatment for multiple myeloma is focused on decreasing the clonal plasma cell population and consequently decrease the symptoms of disease.
Chemotherapy
Initial
Initial treatment of multiple myeloma depends on the person's age and other illnesses present.
The preferred treatment for those under the age of 65 is high-dose chemotherapy, commonly with bortezomib-based regimens, and lenalidomide–dexamethasone,[57] to be followed by a stem cell transplant. A 2016 study concluded that stem cell transplant is the preferred treatment of multiple myeloma.[58] There are two types of stem cell transplants to treat multiple myeloma.[59] In autologous hematopoietic stem-cell transplantation (ASCT) – a person's own stem cells are collected from their own blood, the patient is given high-dose chemotherapy and then the patient's stem cells are transplanted back into the person. It is not curative, but does prolong overall survival and complete remission. In allogeneic stem-cell transplantation, a healthy donor's stem cells are transplanted into the affected person. Allogenic stem-cell transplantation has the potential for a cure, but is used in a very small percentage of people (and in the relapsed setting, not as part of initial treatment).[33] Furthermore, a 5–10% treatment-associated mortality rate is associated with allogeneic stem-cell transplant.
People over age 65 and people with significant concurrent illnesses often cannot tolerate stem-cell transplantation. For these people, the standard of care has been chemotherapy with melphalan and prednisone. Recent studies among this population[60] suggest improved outcomes with new chemotherapy regimens, e.g., with bortezomib.[61] Treatment with bortezomib, melphalan, and prednisone had an estimated overall survival of 83% at 30 months, lenalidomide plus low-dose dexamethasone an 82% survival at 2 years, and melphalan, prednisone, and lenalidomide had a 90% survival at 2 years. Head-to-head studies comparing these regimens have not been performed as of 2008.[62]
There is support for continuous therapies with multiple drug combinations of bortezomib, lenalidomide and thalidomide as initial treatment for transplant-ineligible multiple myeloma.[63]
A 2009 review noted, "Deep venous thrombosis and pulmonary embolism are the major side effects of thalidomide and lenalidomide. Lenalidomide causes more myelosuppression, and thalidomide causes more sedation. Chemotherapy-induced peripheral neuropathy and thrombocytopenia are major side effects of bortezomib."[64]
Treatment of related hyperviscosity syndrome may be required to prevent neurologic symptoms or kidney failure.[65][66]
Maintenance
Most people, including those treated with ASCT, relapse after initial treatment. Maintenance therapy using a prolonged course of low-toxicity medications is often used to prevent relapse. A 2017 meta-analysis showed that post-ASCT maintenance therapy with lenalidomide improved progression-free survival and overall survival in people at standard risk.[67] A 2012 clinical trial showed that people with intermediate- and high-risk disease benefit from a bortezomib-based maintenance regimen.[68]
Relapse
The natural history of myeloma is of relapse following treatment. This may be attributed to tumor heterogeneity. Depending on the person's condition, the prior treatment modalities used and the duration of remission, options for relapsed disease include retreatment with the original agent, use of other agents (such as melphalan, cyclophosphamide, thalidomide, or dexamethasone, alone or in combination), and a second ASCT.
Later in the course of the disease, it becomes refractory (resistant) to formerly effective treatment. This stage is referred to as relapsed/refractory multiple myeloma (RRMM). Treatment modalities that are commonly use to treat RRMM include dexamethasone, proteasome inhibitors (e.g. bortezomib and carfilzomib), immunomodulatory imide drugs (e.g. thalidomide, lenalidomide, and pomalidomide), and certain monoclonal antibodies (e.g. against CD38 and CD319). Survival expectancy has risen in recent years, and new treatments are under development.
Kidney failure in multiple myeloma can be acute (reversible) or chronic (irreversible). Acute kidney failure typically resolves when the calcium and paraprotein levels are brought under control. Treatment of chronic kidney failure is dependent on the type of kidney failure and may involve dialysis.
Several newer options are approved for the management of advanced disease:
- belantamab mafodotin — a monoclonal antibody against B-cell maturation antigen (BCMA), also known as CD269, indicated for the treatment of adults with relapsed or refractory multiple myeloma who have received at least four prior therapies including an anti-CD38 monoclonal antibody, a proteasome inhibitor, and an immunomodulatory agent.[69][70]
- carfilzomib — a proteasome inhibitor that is indicated:
- as a single agent in people who have received one or more lines of therapy
- in combination with dexamethasone or with lenalidomide and dexamethasone in people who have received one to three lines of therapy[71]
- daratumumab — a monoclonal antibody against CD38 indicated in people who have received at least three prior lines of therapy including a proteasome inhibitor and an immunomodulatory agent or who are double refractory to a proteasome inhibitor and an immunomodulatory agent[72]
- elotuzumab — an immunostimulatory humanized monoclonal antibody against SLAMF7 (also known as CD319) indicated in combination with lenalidomide and dexamethasone in people who have received one to three prior therapies[73]
- isatuximab - a monoclonal antibody against CD38 indicated in combination with pomalidomide and dexamethasone for the treatment of adults with multiple myeloma who have received at least two prior therapies including lenalidomide and a proteasome inhibitor.[74][75]
- ixazomib — an orally available proteasome inhibitor indicated in combination with lenalidomide and dexamethasone in people who have received at least one prior therapy[76]
- panobinostat — an orally available histone deacetylase inhibitor used in combination with bortezomib and dexamethasone in people who have received at least two prior chemotherapy regimens, including bortezomib and an immunomodulatory agent[77]
- selinexor — an orally available selective inhibitor of nuclear export indicated in combination with dexamethasone in people who have received at least four prior therapies and whose disease does not respond to at least two proteasome inhibitors, two immunomodulatory agents and an anti-CD38 monoclonal antibody[78]
Stem cell transplant
Stem cell transplant can also be used to treat multiple myeloma.[3] Due to this treatment, a graft-versus-host-disease can occur. Therefore, Fisher et al. conducted a Cochrane review with randomised controlled trials in 2019 to measure the safety and efficacy of mesenchymal stromal cells (MSC) for people suffering from a graft-versus-host disease (GvHD) after receiving a haematopoietic stem cell transplantation as treatment for their haematological disease. Fisher et al. included trials that used MSCs either for therapeutic or prophylactic reasons. The inclusion and exclusion criteria and information regarding the dose can be found in the original Cochrane review. In the therapeutic trials it was necessary that the study participants already suffered from a GvHD. Fisher et al. conducted one analysis: MSCs compared to control/ placebo for treating immune mediated inflammation post-transplantation and in autoimmunity: Mesenchymal stromal cells may reduce the all-cause mortality if they are used for a therapeutic reason. Moreover, the therapeutic use of MSCs may increase the complete response of acute and chronic GvHD, but the evidence is very uncertain. The evidence suggests that MSCs for prophylactic reason result in little to no difference in the all-cause mortality, in the relapse of malignant diseases and in the incidence of acute GvHD. The evidence suggests that MSCs for prophylactic reason reduce the incidence of chronic GvHD.[79]
Other measures
In addition to direct treatment of the plasma cell proliferation, bisphosphonates (e.g., pamidronate or zoledronic acid) are routinely administered to prevent fractures; they have also been observed to have a direct antitumor effect even in people without known skeletal disease. If needed, red blood cell transfusions or erythropoietin can be used for management of anemia.
Palliative care
Multiple national cancer treatment guidelines recommend early palliative care for people with advanced multiple myeloma at the time of diagnosis and for anyone who has significant symptoms.[80][81]
Palliative care is appropriate at any stage of multiple myeloma and can be provided alongside curative treatment. In addition to addressing symptoms of cancer, palliative care helps manage unwanted side effects, such as pain and nausea related to treatments.[82][83]
Teeth
Oral prophylaxis, hygiene instruction and elimination of sources of infection within the mouth before beginning cancer treatment, can reduce the risk of infectious complications. Before starting bisphosphonates therapy, the person's dental health should be evaluated to assess the risk factors to prevent the development of medication-related osteonecrosis of the jaw (MRONJ). If there are any symptoms or radiographic appearance of MRONJ like jaw pain, loose tooth, mucosal swelling, early referral to an oral surgeon is recommended. Dental extractions should be avoided during the active period of treatment and treat the tooth with nonsurgical root canal treatment instead.[84]
Prognosis
Overall the 5-year survival rate is around 54% in the United States.[85] With high-dose therapy followed by ASCT, the median survival has been estimated in 2003 to be about 4.5 years, compared to a median around 3.5 years with "standard" therapy.[86]
The international staging system can help to predict survival, with a median survival (in 2005) of 62 months for stage-1 disease, 45 months for stage-2 disease, and 29 months for stage-3 disease.[52] The average age of onset is 69 years.[85]
Genetic testing
Some myeloma centers now employ genetic testing, which they call a “gene array” . By examining DNA, oncologists can determine if people are at high or low risk of the cancer returning quickly following treatment.
Cytogenetic analysis of myeloma cells may be of prognostic value, with deletion of chromosome 13, nonhyperdiploidy, and the balanced translocations t(4;14) and t(14;16) conferring a poorer prognosis. The 11q13 and 6p21 cytogenetic abnormalities are associated with a better prognosis.
Prognostic markers such as these are always generated by retrospective analyses, and new treatment developments likely will improve the outlook for those with traditionally "poor-risk" disease.
SNP array karyotyping can detect copy number alterations of prognostic significance that may be missed by a targeted FISH panel.[87] In MM, lack of a proliferative clone makes conventional cytogenetics informative in only ~30% of cases.
- Virtual karyotyping identified chromosomal abnormalities in 98% of MM cases
- del(12p13.31) is an independent adverse marker
- amp(5q31.1) is a favorable marker
- The prognostic impact of amp(5q31.1) overrides that of hyperdiploidy and also identifies people who greatly benefit from high-dose therapy.
Array-based karyotyping cannot detect balanced translocations, such as t(4;14) seen in about 15% of MM. Therefore, FISH for this translocation should also be performed if using SNP arrays to detect genome-wide copy number alterations of prognostic significance in MM.
Epidemiology


Globally, multiple myeloma affected 488,000 people and resulted in 101,100 deaths in 2015.[8][9] This is up from 49,000 in 1990.[89]
United States
In the United States in 2016, an estimated 30,330 new cases and 12,650 deaths were reported.[7] These numbers are based on assumptions made using data from 2011, which estimated the number of people affected as 83,367 people, the number of new cases as 6.1 per 100,000 people per year, and the mortality as 3.4 per 100,000 people per year.
Multiple myeloma is the second-most prevalent blood cancer (10%) after non-Hodgkin's lymphoma.[90] It represents about 1.8% of all new cancers and 2.1% of all cancer deaths.[7]
Multiple myeloma affects slightly more men than women. African Americans and native Pacific Islanders have the highest reported number of new cases of this disease in the United States and Asians the lowest. Results of one study found the number of new cases of myeloma to be 9.5 cases per 100,000 African Americans and 4.1 cases per 100,000 Caucasian Americans. Among African Americans, myeloma is one of the top-10 causes of cancer death.
UK
Myeloma is the 17th-most common cancer in the UK: around 4,800 people were diagnosed with the disease in 2011. It is the 16th-most common cause of cancer death: around 2,700 people died of it in 2012.[91]
Other animals
Multiple myeloma has been diagnosed in dogs,[92] cats, and horses.[93]
In dogs, multiple myeloma accounts for around 8% of all haemopoietic tumors. Multiple myeloma occurs in older dogs, and is not particularly associated with either males or females. No breeds appear overrepresented in case reviews that have been conducted.[94] Diagnosis in dogs is usually delayed due to the initial nonspecificity and range of clinical signs possible. Diagnosis usually involves bone-marrow studies, X-rays, and plasma-protein studies. In dogs, protein studies usually reveal the monoclonal gammaglobulin elevation to be IgA or IgG in equal number of cases.[94] In rare cases the globulin elevation is IgM, which is referred to as Waldenström's macroglobulinemia.[95] The prognosis for initial control and return to good quality of life in dogs is good; 43% of dogs started on a combination chemotherapeutic protocol achieved complete remission. Long-term survival is normal, with a median of 540 days reported.[94] The disease eventually recurs, becoming resistant to available therapies. The complications of kidney failure, sepsis, or pain can lead to an animal's death, frequently by euthanasia.
Research
.webp.png)
In terms of research several therapies for multiple myeloma currently being studied:[97][98]
- Carvykti (ciltacabtagene autoleucel or cilta-cel)
- ABBV-383
See also
- Leukemia
- Plasma cell dyscrasia, the spectrum of plasma cell disorders which evolve from benign to malignant conditions
- Development of analogs of thalidomide
- International Myeloma Foundation
- Multiple Myeloma Research Consortium
- Multiple Myeloma Research Foundation
- Waldenström macroglobulinemia
References
- ↑ "Myeloma Canada | What is Multiple Myeloma?". www.myelomacanada.ca. Archived from the original on 13 May 2020. Retrieved 17 April 2020.
- ↑ 2.0 2.1 2.2 2.3 2.4 2.5 2.6 "Plasma Cell Neoplasms (Including Multiple Myeloma)—Patient Version". NCI. 1980-01-01. Archived from the original on 27 July 2016. Retrieved 8 August 2016.
- ↑ 3.00 3.01 3.02 3.03 3.04 3.05 3.06 3.07 3.08 3.09 "Plasma Cell Neoplasms (Including Multiple Myeloma) Treatment (PDQ®)–Health Professional Version". NCI. July 29, 2016. Archived from the original on 4 July 2016. Retrieved 8 August 2016.
- ↑ 4.0 4.1 4.2 World Cancer Report 2014. World Health Organization. 2014. pp. Chapter 5.13. ISBN 978-9283204299.
- ↑ 5.0 5.1 World Cancer Report 2014. World Health Organization. 2014. pp. Chapter 2.3 and 2.6. ISBN 978-9283204299.
- ↑ 6.0 6.1 6.2 6.3 6.4 6.5 6.6 6.7 Raab MS, Podar K, Breitkreutz I, Richardson PG, Anderson KC (July 2009). "Multiple myeloma". Lancet. 374 (9686): 324–39. doi:10.1016/S0140-6736(09)60221-X. PMID 19541364.
- ↑ 7.0 7.1 7.2 7.3 7.4 "SEER Stat Fact Sheets: Myeloma". NCI Surveillance, Epidemiology, and End Results Program. Archived from the original on 27 July 2016. Retrieved 8 August 2016.
- ↑ 8.0 8.1 8.2 GBD 2015 Disease and Injury Incidence and Prevalence, Collaborators. (8 October 2016). "Global, regional, and national incidence, prevalence, and years lived with disability for 310 diseases and injuries, 1990-2015: a systematic analysis for the Global Burden of Disease Study 2015". Lancet. 388 (10053): 1545–1602. doi:10.1016/S0140-6736(16)31678-6. PMC 5055577. PMID 27733282.
{{cite journal}}:|first1=has generic name (help)CS1 maint: numeric names: authors list (link) - ↑ 9.0 9.1 9.2 GBD 2015 Mortality and Causes of Death, Collaborators. (8 October 2016). "Global, regional, and national life expectancy, all-cause mortality, and cause-specific mortality for 249 causes of death, 1980-2015: a systematic analysis for the Global Burden of Disease Study 2015". Lancet. 388 (10053): 1459–1544. doi:10.1016/s0140-6736(16)31012-1. PMC 5388903. PMID 27733281.
{{cite journal}}:|first1=has generic name (help)CS1 maint: numeric names: authors list (link) - ↑ "Plasma Cell Neoplasms (Including Multiple Myeloma) Treatment". National Cancer Institute. 1980-01-01. Archived from the original on 2021-01-09. Retrieved 28 November 2017.
- ↑ Ferri, Fred F. (2013). Ferri's Clinical Advisor 2014 E-Book: 5 Books in 1. Elsevier Health Sciences. p. 726. ISBN 978-0323084314. Archived from the original on 2019-09-17. Retrieved 2020-08-06.
- ↑ van de Donk NW, Mutis T, Poddighe PJ, Lokhorst HM, Zweegman S (2016). "Diagnosis, risk stratification and management of monoclonal gammopathy of undetermined significance and smoldering multiple myeloma". International Journal of Laboratory Hematology. 38 Suppl 1: 110–22. doi:10.1111/ijlh.12504. PMID 27161311.
- ↑ Diepenbrock, Nancy H. (2011). Quick Reference to Critical Care. Lippincott Williams & Wilkins. p. 292. ISBN 9781608314645. Archived from the original on 2016-08-21.
- ↑ Albagoush, Sara A.; Shumway, Cameron; Azevedo, Alexandre M. (30 January 2023). "Multiple Myeloma". StatPearls. StatPearls Publishing. Retrieved 16 August 2025.
- ↑ 15.0 15.1 15.2 International Myeloma Working Group (2003). "Criteria for the classification of monoclonal gammopathies, multiple myeloma and related disorders: a report of the International Myeloma Working Group". Br. J. Haematol. 121 (5): 749–57. doi:10.1046/j.1365-2141.2003.04355.x. PMID 12780789. Archived from the original on 2020-07-31. Retrieved 2020-08-06.
- ↑ Longo, Dan (2012). Harrison's Principles of Internal Medicine 18th Edition. Mc Graw Hill Medical. p. 938. ISBN 978-0-07-174889-6.
- ↑ 17.0 17.1 Nasr SH, Said SM, Valeri AM, Sethi S, Fidler ME, Cornell LD, Gertz MA, Dispenzieri A, Buadi FK, Vrana JA, Theis JD, Dogan A, Leung N (2013). "The diagnosis and characteristics of renal heavy-chain and heavy/light-chain amyloidosis and their comparison with renal light-chain amyloidosis". Kidney International. 83 (3): 463–70. doi:10.1038/ki.2012.414. PMID 23302715.
- ↑ Castillo JJ (2016). "Plasma Cell Disorders". Primary Care. 43 (4): 677–691. doi:10.1016/j.pop.2016.07.002. PMID 27866585.
- ↑ Chapel HM, Lee M (1994). "The use of intravenous immune globulin in multiple myeloma". Clin. Exp. Immunol. 97 (Suppl 1): 21–4. PMC 1550368. PMID 8033429.
- ↑ Hargreaves RM, Lea JR, Griffiths H, et al. (1995). "Immunological factors and risk of infection in plateau phase myeloma (stable phase)" (PDF). J. Clin. Pathol. 48 (3): 260–6. doi:10.1136/jcp.48.3.260. PMC 502468. PMID 7730490. Archived from the original on 2008-05-04.
- ↑ Glick, Michael, editor. (January 2015). Burket's oral medicine. ISBN 978-1-60795-188-9. OCLC 888026338.
{{cite book}}:|last=has generic name (help)CS1 maint: multiple names: authors list (link) - ↑ Landgren O, Kyle RA, Pfeiffer RM, Katzmann JA, Caporaso NE, Hayes RB, Dispenzieri A, Kumar S, Clark RJ, Baris D, Hoover R, Rajkumar SV (28 May 2009). "Monoclonal gammopathy of undetermined significance (MGUS) consistently precedes multiple myeloma: a prospective study". Blood. 113 (22): 5412–7. doi:10.1182/blood-2008-12-194241. PMC 2689042. PMID 19179464.
- ↑ 23.0 23.1 23.2 Dutta AK, Hewett DR, Fink JL, Grady JP, Zannettino AC (2017). "Cutting edge genomics reveal new insights into tumour development, disease progression and therapeutic impacts in multiple myeloma". British Journal of Haematology. 178 (2): 196–208. doi:10.1111/bjh.14649. PMID 28466550.
- ↑ 24.0 24.1 Willrich MA, Murray DL, Kyle RA (2018). "Laboratory testing for monoclonal gammopathies: Focus on monoclonal gammopathy of undetermined significance and smoldering multiple myeloma". Clinical Biochemistry. 51: 38–47. doi:10.1016/j.clinbiochem.2017.05.001. PMID 28479151.
- ↑ Roberts, DL; Dive, C; Renehan, AG (2010). "Biological mechanisms linking obesity and cancer risk: new perspectives". Annual Review of Medicine. 61: 301–16. doi:10.1146/annurev.med.080708.082713. PMID 19824817.
- ↑ 26.0 26.1 Koura DT, Langston AA (August 2013). "Inherited predisposition to multiple myeloma". Therapeutic Advances in Hematology. 4 (4): 291–7. doi:10.1177/2040620713485375. PMC 3734900. PMID 23926460.
- ↑ Schinasi LH (2016). "Multiple myeloma and family history of lymphohaematopoietic cancers: Results from the International Multiple Myeloma Consortium". BJH. 175 (1): 87–101. doi:10.1111/bjh.14199. PMC 5035512. PMID 27330041.
- ↑ Sekiguchi Y, Shimada A, Ichikawa K, Wakabayashi M, Sugimoto K, Ikeda K, Sekikawa I, Tomita S, Izumi H, Nakamura N, Sawada T, Ohta Y, Komatsu N, Noguchi M (2015). "Epstein-Barr virus-positive multiple myeloma developing after immunosuppressant therapy for rheumatoid arthritis: a case report and review of literature". International Journal of Clinical and Experimental Pathology. 8 (2): 2090–102. PMC 4396324. PMID 25973110.
- ↑ 29.0 29.1 Rezk SA, Zhao X, Weiss LM (June 2018). "Epstein - Barr virus - associated lymphoid proliferations, a 2018 update". Human Pathology. 79: 18–41. doi:10.1016/j.humpath.2018.05.020. PMID 29885408.
- ↑ 30.0 30.1 Yan J, Wang J, Zhang W, Chen M, Chen J, Liu W (April 2017). "Solitary plasmacytoma associated with Epstein-Barr virus: a clinicopathologic, cytogenetic study and literature review". Annals of Diagnostic Pathology. 27: 1–6. doi:10.1016/j.anndiagpath.2016.09.002. PMID 28325354.
- ↑ Dojcinov SD, Fend F, Quintanilla-Martinez L (March 2018). "EBV-Positive Lymphoproliferations of B- T- and NK-Cell Derivation in Non-Immunocompromised Hosts". Pathogens (Basel, Switzerland). 7 (1): 28. doi:10.3390/pathogens7010028. PMC 5874754. PMID 29518976.
{{cite journal}}: CS1 maint: unflagged free DOI (link) - ↑ Federico Caligaris-Cappio; Manlio Ferrarini (1997). Human B Cell Populations. Chemical Immunology. Vol. 67. Switzerland: S. Karger AG. p. 105. ISBN 978-3-8055-6460-1. Archived from the original on 2016-05-27.
- ↑ 33.0 33.1 Kyle RA, Rajkumar SV (2004). "Multiple myeloma". N. Engl. J. Med. 351 (18): 1860–73. doi:10.1056/NEJMra041875. PMID 15509819.
- ↑ Tricot G (2000). "New insights into role of microenvironment in multiple myeloma". Lancet. 355 (9200): 248–50. doi:10.1016/S0140-6736(00)00019-2. PMID 10675068.
- ↑ Agirre, Xabier; Castellano, Giancarlo; Pascual, Marien; Heath, Simon; Kulis, Marta; Segura, Victor; Bergmann, Anke; Esteve, Anna; Merkel, Angelika (2015-04-01). "Whole-epigenome analysis in multiple myeloma reveals DNA hypermethylation of B cell-specific enhancers". Genome Research. 25 (4): 478–487. doi:10.1101/gr.180240.114. ISSN 1088-9051. PMC 4381520. PMID 25644835.
- ↑ 36.0 36.1 Weaver, CJ; Tariman, JD (18 July 2017). "Multiple Myeloma Genomics: A Systematic Review". Seminars in Oncology Nursing. 33 (3): 237–253. doi:10.1016/j.soncn.2017.05.001. PMID 28729121. Archived from the original on 18 July 2020. Retrieved 6 August 2020.
- ↑ 37.0 37.1 Fernández de Larrea C, Kyle RA, Durie BG, Ludwig H, Usmani S, Vesole DH, Hajek R, San Miguel JF, Sezer O, Sonneveld P, Kumar SK, Mahindra A, Comenzo R, Palumbo A, Mazumber A, Anderson KC, Richardson PG, Badros AZ, Caers J, Cavo M, LeLeu X, Dimopoulos MA, Chim CS, Schots R, Noeul A, Fantl D, Mellqvist UH, Landgren O, Chanan-Khan A, Moreau P, Fonseca R, Merlini G, Lahuerta JJ, Bladé J, Orlowski RZ, Shah JJ (2013). "Plasma cell leukemia: consensus statement on diagnostic requirements, response criteria and treatment recommendations by the International Myeloma Working Group". Leukemia. 27 (4): 780–91. doi:10.1038/leu.2012.336. PMC 4112539. PMID 23288300.
- ↑ Simeon V, Todoerti K, La Rocca F, Caivano A, Trino S, Lionetti M, Agnelli L, De Luca L, Laurenzana I, Neri A, Musto P (2015). "Molecular Classification and Pharmacogenetics of Primary Plasma Cell Leukemia: An Initial Approach toward Precision Medicine". International Journal of Molecular Sciences. 16 (8): 17514–34. doi:10.3390/ijms160817514. PMC 4581206. PMID 26263974.
{{cite journal}}: CS1 maint: unflagged free DOI (link) - ↑ Lonial, Sagar, and Jonathan L. Kaufman. "Non-secretory myeloma: a clinician's guide." Oncology (Williston Park, NY) 27.9 (2013): 924-8.
- ↑ Mitchell, Richard Sheppard; Kumar, Vinay; Abbas, Abul K.; Fausto, Nelson (2007). "Multiple myeloma". Robbins Basic Pathology (8th ed.). Philadelphia: Saunders. p. 455. ISBN 978-1-4160-2973-1.
- ↑ Rajkumar, S. Vincent (2005-01-01). "MGUS and Smoldering Multiple Myeloma: Update on Pathogenesis, Natural History, and Management". ASH Education Program Book. 2005 (1): 340–345. doi:10.1182/asheducation-2005.1.340. ISSN 1520-4391. PMID 16304401.
- ↑ 42.0 42.1 42.2 42.3 Rajkumar, S Vincent; Dimopoulos, Meletios A; Palumbo, Antonio; Blade, Joan; Merlini, Giampaolo; Mateos, María-Victoria; Kumar, Shaji; Hillengass, Jens; Kastritis, Efstathios (November 2014). "International Myeloma Working Group updated criteria for the diagnosis of multiple myeloma". The Lancet Oncology. 15 (12): e538 – e548. doi:10.1016/s1470-2045(14)70442-5. ISSN 1470-2045. PMID 25439696. Archived from the original on 2017-12-23. Retrieved 2020-08-06.
- ↑ "Robbins & Cotran Pathologic Basis of Disease - 9781455726134 | US Elsevier Health Bookshop". www.us.elsevierhealth.com. Archived from the original on 2021-04-30. Retrieved 2016-10-26.
- ↑ Klatt, Edward C. (2011-09-08). Robbins and Cotran Atlas of Pathology. Elsevier Health Sciences. ISBN 978-1455726837. Archived from the original on 2017-09-10.
- ↑ Frigyesi I (Jan 2014). "Robust isolation of malignant plasma cells in multiple myeloma". Blood. 123 (9): 1336–40. doi:10.1182/blood-2013-09-529800. PMID 24385542.
- ↑ "Mayo Stratification for Myeloma And Risk-adapted Therapy". nebula.wsimg.com. Archived from the original on 28 August 2021. Retrieved 29 September 2017.
- ↑ Sonneveld, P.; Avet-Loiseau, H.; Lonial, S.; Usmani, S.; Siegel, D.; Anderson, K. C.; Chng, W.-J.; Moreau, P.; Attal, M.; Kyle, R. A.; Caers, J.; Hillengass, J.; San Miguel, J.; Van De Donk, N. W. C. J.; Einsele, H.; Blade, J.; Durie, B. G. M.; Goldschmidt, H.; Mateos, M.-V.; Palumbo, A.; Orlowski, R. (2016). "Treatment of multiple myeloma with high-risk cytogenetics: A consensus of the International Myeloma Working Group". Blood. 127 (24): 2955–2962. doi:10.1182/blood-2016-01-631200. PMC 4920674. PMID 27002115.
- ↑ Angtuaco, Edgardo J. C.; Fassas, Athanasios B. T.; Walker, Ronald; Sethi, Rajesh; Barlogie, Bart (2004). "Multiple Myeloma: Clinical Review and Diagnostic Imaging". Radiology. 231 (1): 11–23. doi:10.1148/radiol.2311020452. ISSN 0033-8419. PMID 14990813.
- ↑ Nishida, Yuki; Kimura, Shinya; Mizobe, Hideaki; Yamamichi, Junta; Kojima, Kensuke; Kawaguchi, Atsushi; Fujisawa, Manabu; Matsue, Kosei (2017). "Automatic digital quantification of bone marrow myeloma volume in appendicular skeletons - clinical implications and prognostic significance". Scientific Reports. 7 (1): 12885. doi:10.1038/s41598-017-13255-w. ISSN 2045-2322. PMC 5635114. PMID 29018236.
- ↑ Kyle RA, Rajkumar SV (January 2009). "Criteria for diagnosis, staging, risk stratification and response assessment of multiple myeloma". Leukemia. 23 (1): 3–9. doi:10.1038/leu.2008.291. PMC 2627786. PMID 18971951.
- ↑ 51.0 51.1 51.2 "International Myeloma Working Group (IMWG) Criteria for the Diagnosis of Multiple Myeloma". International Myeloma Working Group. 2015-10-29. Archived from the original on 2017-11-07. Retrieved 2018-08-05.
- ↑ 52.0 52.1 Greipp PR, San Miguel J, Durie BG, et al. (2005). "International staging system for multiple myeloma". J. Clin. Oncol. 23 (15): 3412–20. doi:10.1200/JCO.2005.04.242. PMID 15809451.
- ↑ Durie BG, Salmon SE (1975). "A clinical staging system for multiple myeloma. Correlation of measured myeloma cell mass with presenting clinical features, response to treatment, and survival". Cancer. 36 (3): 842–54. doi:10.1002/1097-0142(197509)36:3<842::AID-CNCR2820360303>3.0.CO;2-U. PMID 1182674.
- ↑ Lauby-Secretan, B; Scoccianti, C; Loomis, D; Grosse, Y; Bianchini, F; Straif, K; International Agency for Research on Cancer Handbook Working, Group (25 August 2016). "Body Fatness and Cancer - Viewpoint of the IARC Working Group". The New England Journal of Medicine. 375 (8): 794–798. doi:10.1056/NEJMsr1606602. PMC 6754861. PMID 27557308. Archived from the original on 28 August 2021. Retrieved 6 August 2020.
{{cite journal}}:|first7=has generic name (help) - ↑ Su, Christopher T.; Ye, J. Christine (23 July 2021). "Emerging therapies for relapsed/refractory multiple myeloma: CAR-T and beyond". Journal of Hematology & Oncology. 14 (1): 115. doi:10.1186/s13045-021-01109-y. ISSN 1756-8722.
{{cite journal}}: CS1 maint: unflagged free DOI (link) - ↑ Korde N, Kristinsson SY, Landgren O (2011). "Monoclonal gammopathy of undetermined significance (MGUS) and smoldering multiple myeloma (SMM): novel biological insights and development of early treatment strategies". Blood. 117 (21): 5573–5581. doi:10.1182/blood-2011-01-270140. PMC 3316455. PMID 21441462.
- ↑ Kyle RA, Rajkumar SV (2008). "Multiple myeloma". Blood. 111 (6): 2962–72. doi:10.1182/blood-2007-10-078022. PMC 2265446. PMID 18332230.
- ↑ Printz, Carrie (2016-09-20). "Study: Stem cell transplant should remain preferred therapy for multiple myeloma". Cancer. 122 (19): 2937–2937. doi:10.1002/cncr.30334. ISSN 0008-543X.
- ↑ "Stem Cell Transplant for Multiple Myeloma". www.cancer.org. Archived from the original on 2019-10-13. Retrieved 2019-10-13.
- ↑ San Miguel, J.F.; et al. (2008). "Bortezomib plus Melphalan and Prednisone for Initial Treatment of Multiple Myeloma" (PDF). N. Engl. J. Med. 359 (9): 906–917. doi:10.1056/NEJMoa0801479. hdl:10261/59573. PMID 18753647. Archived (PDF) from the original on 2021-04-20. Retrieved 2020-08-06.
- ↑ Curran M, McKeage K (2009). "Bortezomib: A Review of its Use in Patients with Multiple Myeloma". Drugs. 69 (7): 859–888. doi:10.2165/00003495-200969070-00006. PMID 19441872. Archived from the original on 2011-10-08. Retrieved 2012-12-15.
- ↑ Durie, B.G.M. (2008). "Treatment of Myeloma — Are We Making Progress?". N. Engl. J. Med. 359 (9): 964–6. doi:10.1056/NEJMe0805176. PMID 18753654.
- ↑ Piechotta, Vanessa; Jakob, Tina; Langer, Peter; Monsef, Ina; Scheid, Christof; Estcourt, Lise J; Ocheni, Sunday; Theurich, Sebastian; Kuhr, Kathrin; Scheckel, Benjamin; Adams, Anne (2019-11-25). Cochrane Haematology Group (ed.). "Multiple drug combinations of bortezomib, lenalidomide, and thalidomide for first-line treatment in adults with transplant-ineligible multiple myeloma: a network meta-analysis". Cochrane Database of Systematic Reviews. 2019 (11). doi:10.1002/14651858.CD013487. PMC 6876545. PMID 31765002.
- ↑ Abraham J (2009). "Advances in multiple myeloma treatment: lenalidomide and bortezomib" (PDF). Community Oncology. 6 (2): 53–55. doi:10.1016/S1548-5315(11)70208-X. Archived from the original (PDF) on 2010-10-19. Retrieved 2010-09-17.
- ↑ Johnson WJ, Kyle RA, Pineda AA, O'Brien PC, Holley KE (April 1990). "Treatment of renal failure associated with multiple myeloma. Plasmapheresis, hemodialysis, and chemotherapy". Arch. Intern. Med. 150 (4): 863–9. doi:10.1001/archinte.1990.00390160111022. PMID 2183734.
- ↑ Paul M, Walker F, Bear RA (November 1982). "Plasmapheresis therapy in a patient with multiple myeloma". Can. Med. Assoc. J. 127 (10): 956. PMC 1862296. PMID 7139441.
- ↑ McCarthy, P. L; Holstein, S. A; Petrucci, M. T; Richardson, P. G; Hulin, C; Tosi, P; Bringhen, S; Musto, P; Anderson, K. C; Caillot, D; Gay, F; Moreau, P; Marit, G; Jung, S. H; Yu, Z; Winograd, B; Knight, R. D; Palumbo, A; Attal, M (July 27, 2017). "Lenalidomide Maintenance After Autologous Stem Cell Transplant in Newly Diagnosed Multiple Myeloma: a Meta-Analysis". J Clin Oncol. 35 (29): 3279–3289. doi:10.1200/JCO.2017.72.6679. PMC 5652871. PMID 28742454.
- ↑ Sonneveld, P (July 16, 2012). "Bortezomib induction and maintenance treatment in patients with newly diagnosed multiple myeloma". J Clin Oncol. 30 (24): 2946–55. doi:10.1200/JCO.2011.39.6820. hdl:1765/73197. PMID 22802322. Archived from the original on August 9, 2020. Retrieved August 6, 2020.
- ↑ "FDA granted accelerated approval to belantamab mafodotin-blmf for multiple myeloma". U.S. Food and Drug Administration (FDA). 5 August 2020. Archived from the original on 6 August 2020. Retrieved 6 August 2020.
 This article incorporates text from this source, which is in the public domain.
This article incorporates text from this source, which is in the public domain.
- ↑ "FDA Approves GSK's BLENREP (belantamab mafodotin-blmf) for the Treatment of Patients with Relapsed or Refractory Multiple Myeloma" (Press release). GlaxoSmithKline. 6 August 2020. Archived from the original on 6 August 2020. Retrieved 6 August 2020 – via Business Wire.
- ↑ "Kyprolis (carfilzomib) for Injection, for Intravenous Use. Full Prescribing Information" (PDF). Onyx Pharmaceuticals, Inc. Thousand Oaks, CA 91320-1799 U.S.A. Archived from the original (PDF) on 23 October 2016. Retrieved 20 August 2016.
- ↑ "Darzalex (daratumumab) Injection, for Intravenous Use. Full Prescribing Information" (PDF). Janssen Biotech, Inc. Horsham, PA 19044. Archived from the original (PDF) on 18 August 2016. Retrieved 18 August 2016.
- ↑ "Empliciti (elotuzumab) for Injection, for Intravenous Use. Full Prescribing Information" (PDF). Bristol-Myers Squibb Company. Princeton, NJ 08543 USA. Archived from the original (PDF) on 8 December 2015. Retrieved 18 August 2016.
- ↑ "FDA approves isatuximab-irfc for multiple myeloma". U.S. Food and Drug Administration (FDA). 2 March 2020. Archived from the original on 5 March 2020. Retrieved 2 March 2020.
- ↑ Martin TG, Corzo K, Chiron M (2019). "Therapeutic Opportunities with Pharmacological Inhibition of CD38 with Isatuximab". CELLS. 8 (12): 1522. doi:10.3390/cells8121522. PMC 6953105. PMID 31779273. Archived from the original on 2020-03-20. Retrieved 2020-08-06.
{{cite journal}}: CS1 maint: unflagged free DOI (link) - ↑ "Ninlaro (ixazomib) Capsules, for Oral Use. Full Prescribing Information" (PDF). Millennium Pharmaceuticals, Inc. Archived from the original (PDF) on 19 August 2016. Retrieved 18 August 2016.
- ↑ "Farydak (panobinostat) Capsules, for Oral Use. Full Prescribing Information" (PDF). Novartis Pharmaceuticals Corporation. East Hanover, New Jersey 07936. Archived from the original (PDF) on 22 October 2016. Retrieved 18 August 2016.
- ↑ "Xpovio (selinexor) Tablets, for Oral Use. Full Prescribing Information" (PDF). Karyopharm Therapeutics Inc. 85 Wells Avenue, Newton, MA, 02459. Archived from the original (PDF) on 3 August 2019. Retrieved 3 August 2019.
- ↑ Fisher, Sheila A; Cutler, Antony; Doree, Carolyn; Brunskill, Susan J; Stanworth, Simon J; Navarrete, Cristina; Girdlestone, John (2019-01-30). Cochrane Haematological Malignancies Group (ed.). "Mesenchymal stromal cells as treatment or prophylaxis for acute or chronic graft-versus-host disease in haematopoietic stem cell transplant (HSCT) recipients with a haematological condition". Cochrane Database of Systematic Reviews. doi:10.1002/14651858.CD009768.pub2. Archived from the original on 2021-08-27. Retrieved 2020-08-06.
- ↑ The American Society of Clinical Oncology has made this recommendation based on various cancers. See American Society of Clinical Oncology, "Five Things Physicians and Patients Should Question" (PDF), Choosing Wisely: an initiative of the ABIM Foundation, American Society of Clinical Oncology, archived from the original (PDF) on July 31, 2012, retrieved August 14, 2012
- ↑ Snowden JA, Ahmedzai S, Ashcroft J, et al. (2010). "Guidelines for Supportive Care in Myeloma" (PDF). British Committee for Standards in Haematology. Archived (PDF) from the original on 2015-09-23.
- ↑ Higginson IJ, Evans CJ (2010). "What is the evidence that palliative care teams improve outcomes for cancer patients and their families?". Cancer J. 16 (5): 423–35. doi:10.1097/PPO.0b013e3181f684e5. PMID 20890138.
- ↑ Lorenz KA, Lynn J, Dy SM, Shugarman LR, Wilkinson A, Mularski RA, et al. (2008). "Evidence for improving palliative care at the end of life: a systematic review". Ann. Intern. Med. 148 (2): 147–59. doi:10.7326/0003-4819-148-2-200801150-00010. PMID 18195339.
- ↑ Abed, Hassan; Burke, Mary; Nizarali, Najla (2018-05-02). "Oral and dental management for people with multiple myeloma: clinical guidance for dental care providers". Dental Update. 45 (5): 383–399. doi:10.12968/denu.2018.45.5.383. ISSN 0305-5000.
- ↑ 85.0 85.1 "Myeloma - Cancer Stat Facts". SEER. Archived from the original on 7 May 2020. Retrieved 17 April 2020.
- ↑ Child JA, Morgan GJ, Davies FE, et al. (May 2003). "High-dose chemotherapy with hematopoietic stem-cell rescue for multiple myeloma". N. Engl. J. Med. 348 (19): 1875–1883. doi:10.1056/NEJMoa022340. PMID 12736280. Archived from the original on 2021-06-04. Retrieved 2020-08-06.
- ↑ Avet-Loiseau H, Li C, Magrangeas F, et al. (September 2009). "Prognostic significance of copy-number alterations in multiple myeloma". J. Clin. Oncol. 27 (27): 4585–90. doi:10.1200/JCO.2008.20.6136. PMC 2754906. PMID 19687334.
- ↑ "WHO Disease and injury country estimates". World Health Organization. 2009. Archived from the original on 2009-11-11. Retrieved Nov 11, 2009.
- ↑ GBD 2013 Mortality and Causes of Death, Collaborators (10 January 2015). "Global, regional, and national age-sex specific all-cause and cause-specific mortality for 240 causes of death, 1990-2013: a systematic analysis for the Global Burden of Disease Study 2013". Lancet. 385 (9963): 117–71. doi:10.1016/s0140-6736(14)61682-2. PMC 4340604. PMID 25530442.
{{cite journal}}:|first1=has generic name (help)CS1 maint: numeric names: authors list (link) - ↑ Collins CD (2005). "Problems monitoring response in multiple myeloma". Cancer Imaging. 5 (Spec No A): S119–26. doi:10.1102/1470-7330.2005.0033. PMC 1665317. PMID 16361127.
- ↑ "Myeloma statistics". Cancer Research UK. Archived from the original on 28 October 2014. Retrieved 28 October 2014.
- ↑ Ettinger, Stephen J.; Feldman, Edward C. (1 June 2000). Textbook of Veterinary Internal Medicine: Diseases of the Dog and Cat. Vol. 1. W.B. Saunders. pp. 516–9. ISBN 978-0-7216-7257-1.
- ↑ MacAllister C, Qualls C, Tyler R, Root CR (August 1987). "Multiple myeloma in a horse". J. Am. Vet. Med. Assoc. 191 (3): 337–9. PMID 3654300.
- ↑ 94.0 94.1 94.2 Matus, R.E.; Leifer, C.E.; MacEwen, E.G.; Hurvitz, A.I. (1986). "Prognostic factors for multiple myeloma in the dog". J. Am. Vet. Med. Assoc. 188 (11): 1288–92. PMID 3721983.
- ↑ MacEwan, E.G.; Hurvitz, A.I. (1977). "Diagnosis and Management of Monoclonal Gammopathies". Veterinary Clinics of North America. 7 (1): 119–32. doi:10.1016/S0091-0279(77)50010-X. PMID 403649.
- ↑ Su, Christopher T.; Ye, J. Christine (23 July 2021). "Emerging therapies for relapsed/refractory multiple myeloma: CAR-T and beyond". Journal of Hematology & Oncology. 14 (1): 115. doi:10.1186/s13045-021-01109-y. ISSN 1756-8722.
{{cite journal}}: CS1 maint: unflagged free DOI (link) - ↑ "FDA Approves Carvykti CAR T-Cell Therapy for Multiple Myeloma - NCI". www.cancer.gov. 30 March 2022. Archived from the original on 10 June 2023. Retrieved 6 July 2024.
- ↑ D'Souza, Anita; Shah, Nina; Rodriguez, Cesar; Voorhees, Peter M.; Weisel, Katja; Bueno, Orlando F.; Pothacamury, Rajvineeth K.; Freise, Kevin J.; Yue, Susan; Ross, Jeremy A.; Polepally, Akshanth R.; Talati, Chetasi; Lee, Shane; Jin, Ziyi; Buelow, Ben; Vij, Ravi; Kumar, Shaji (1 November 2022). "A Phase I First-in-Human Study of ABBV-383, a B-Cell Maturation Antigen × CD3 Bispecific T-Cell Redirecting Antibody, in Patients With Relapsed/Refractory Multiple Myeloma". Journal of Clinical Oncology. 40 (31): 3576–3586. doi:10.1200/JCO.22.01504. ISSN 0732-183X. Archived from the original on 21 April 2023. Retrieved 6 July 2024.
External links
| Classification | |
|---|---|
| External resources |
- Multiple myeloma at Curlie